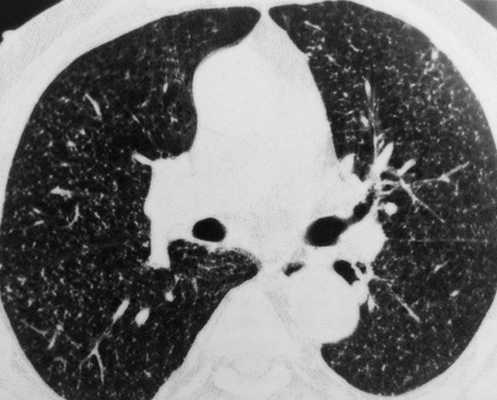
Туберкулез легких на КТ (множественные очаги)

Визуализирующие исследования органов грудной клетки
Добавил пользователь Валентин П. Обновлено: 22.12.2025
Необходимость в том или ином обследовании легких возникает не только при проявлении симптомов респираторного заболевания (кашель, одышка, проблемы с дыханием), но и в профилактических целях. Ежегодная флюорография направлена на своевременное выявление туберкулеза, вызванного палочкой Коха, которые присутствуют в организме каждого человека в «спящей» форме. Компьютерная томография легких (МСКТ) достоверно снижает смертность от пневмонии и рака легких, поскольку позволяет визуализировать патологические очаги, опухоли и метастазы даже очень небольших размеров. В этой статье мы рассмотрим, какие виды обследования легких существуют и расскажем о каждом из них подробнее.
Лучевая диагностика
К этой группе относятся неинвазивные и безболезненные методы диагностики с применением определенных видов излучения, технологий визуализации и обработки изображений. Такие исследования основаны на принципе разного ответа разных по плотности внутренних органов и тканей. Полученные изображения чем-то напоминают географические карты, только вместо ландшафтов на них темными и светлыми цветами обозначены анатомические структуры. На таких изображениях врачи видят патологические изменения: увеличенные лимфоузлы, опухоли, переломы ребер, инфекционно-воспалительные очаги и другие отклонения от нормы, характерные для той или иной болезни: эмфизема, интерстициальное заболевание легких, муковисцидоз и др.
КТ (МСКТ) грудной клетки
Современный высокоточный метод посрезового сканирования с использованием рентгеновского (x-ray) излучения и возможностью построения аутентичной 3D-модели костей, дыхательных путей, внутренних органов и сосудов. Преимущество компьютерной томографии заключается в том, что за несколько секунд томограф делает множество сканов, которые затем можно объединить в объемное изображение. Исследуют ткани любой морфологии: губчатую паренхиму легких, кости, органы.
При сканировании грудной клетки в область обзора попадают легкие, трахея, бронхиальное дерево, средостений, грудной отдел позвоночника и ребра. Для обследования сосудов и при подозрении на наличие онкологических опухолей проводится КТ грудной клетки с контрастом. Суть контрастирования заключается в том, что пациенту в плечевую вену предварительно вводится специальный препарат, который дополнительно «окрашивает» стенки сосудов и вен, а также позволяет визуализировать новообразования, уточнить их размер, а иногда и специфику (предварительно, для уточнения потребуется биопсия).
Компьютерная томография легких лучше чем другие виды диагностики показывает пневмонии, туберкулез, опухоли легких и средостения (в т.ч. тимомы), травмы ребер и грудного отдела позвоночника.
На КТ с контрастом в высоком разрешении визуализируются легочная артерия и грудная аорта. Врачи-рентгенологи видят мальформации, аневризмы, повреждения и сужение просвета сосудов в связи с тромбозом, атеросклерозом, компрессией и т.д.
Однако КТ грудной клетки не покажет грыжи межпозвонковых дисков. Для их диагностики подойдет МРТ.
МРТ грудной клетки
Магнитно-резонансная томография грудной клетки также относится к современным, информативным и сложным методам обследования, который позволяет осмотреть внутренние органы в высоком разрешении, в разных проекциях и воссоздать 3D-реконструкцию на основании множества томограмм. МРТ как правило применяется для исследования органов средостения. МРТ не подходит для исследования ребер, визуализации мелких очагов в паренхиме лекгих.
Ядра атомов водорода в организме человека, если на них воздействуют радиочастотные импульсы в магнитном поле, подают особые эхо-сигналы, которые можно использовать для визуализации внутренних органов во всех плоскостях и проекциях. Этот принцип заложен в основу МРТ-диагностики.
В отличие от КТ-обследования, основанного на ионизирующем облучении, магнитно-резонансная томография базируется на электромагнитном излучении, не оказывающем влияния на организм. Обследование можно проходить сколько угодно раз, и беременным женщинам (при наличии показаний) оно не противопоказано. МРТ нельзя проводить пациентам с протезами клапанов сердца и кардиостимуляторами (необходима консультация врача).
УЗИ грудной клетки
Ультразвуковое исследование грудной клетки назначается с целью визуальной оценки серозной оболочки дыхательных органов и плевральной полости, стенок грудной клетки, а именно для уточнения ее объема, целостности, наличия или отсутствия лишней жидкости, посторонних предметов. Женщинам в возрасте до 35 лет рекомендуется ежегодно в профилактических целях делать УЗИ молочных желез.
Преимущество этого метода заключается в том, что ультразвуковые волны абсолютно безопасны для организма человека. Эти же волны используют летучие мыши, чтобы ориентироваться в пространстве. Производимые УЗ-сигналы отражаются окружающими объектами и возвращаются к хищнику вместе с информацией, необходимой, чтобы обходить в темноте препятствия и охотитьсяю. УЗИ грудной клетки показывает опухоли молочных желез и стенок грудной клетки, скопление жидкости в плевре.
Обследование назначается при подозрении на онкологию и другие заболевания. Специальная подготовка не требуется. УЗИ стенкок грудной клетки делают на вдохе, пациенту нужно задержать дыхание на несколько секунд и поднять руки.

ЭХОКГ (УЗИ сердца)
Эхокардиография назначается пациентам с определенными патологиями легких. Функциональная диагностика сердца позволяет в реальном времени оценить деформацию каждого сегмента и клапана. Врачи рекомендуют проходить УЗИ сердца, например, при пневмонии, если пациент находится в группе риска по сердечно-сосудистым заболеваниям, или его беспокоят симптомы, характерные для миокардита, заболеваний миокарда, легочной эмболии.
Сердце и легкие расположены близко и работают «сообща»: легкие получают кислород, который с кровью транспортируется к сердцу. Сердце поставляет кровь, насыщенную кислородом, к другим органам и тканям, которым она необходима для энергии и поддержания жизнедеятельности.
У сердечной недостаточности и заболеваний легких есть один общий симптом — затрудненное дыхание. В этой связи важно понять, работа какого органа и почему нарушена.
При легочной гипертензии (заболевание вызвано закрытием просвета средних и мелких сосудов легких) пациентов обычно беспокоит быстрая утомляемость, дискомфорт или боль в левой части грудной клетки. Однако основной причиной легочной гипертензии является поражение сердечной мышцы (левых камер) на фоне ишемии, воспалительных заболеваний миокарда, пороков сердца. УЗИ (ЭхоКГ) сердца при легочной гипертензии позволяет оценить состояние внутреннего органа (клапанов и желудочков сердца, проходимость артериальных протоков).
Рентген грудной клетки
Доза рентгеновского облучения при стандартной рентгенографии крайне мала и составляет всего около 0,03 — 0,3 мЗв. Обследование назначается при подозрении на перелом костей (ребер, ключицы), а также если у врача-терапевта или пульмонолога есть подозрения на патологию легких.
Однако разрешающей способности рентгена и двухмерной техники визуализации не всегда достаточно для точной визуальной оценки дыхательного органа. Например, по статистике ВОЗ, выявляемость пневмонии, ассоциированной с вирусом SARS-Cov2, на рентгене всего 50-60%, в то же время на КТ — 95%.

Флюорография
Относится к рентгенологическим исследованиям с лучевой нагрузкой, приблизительно равной 0,03 - 0,05 мЗв за одно исследование грудной клетки. Флюорография рекомендована в качестве ежегодного профилактического обследования, поскольку эффективно показывает туберкулез легких — заболевание, вызываемое палочками Коха, которые присутствуют в организме каждого человека в неактивной «спящей» форме.
На флюорографии выявляют опухоли и пневмонии, однако также как и в случае с рентгеном, 2D-техника визуализация, сравнительно небольшой поток рентгеновских лучей, эффект «наложения теней» не позволяют увидеть всех подробностей. Например, опухоли 3-5 мм и свежие «матовые стекла» на флюорографическом снимке с высокой долей вероятности заметны не будут.
Тем не менее, профилактическая флюорография может спасти человеку жизнь и остановить распространение туберкулезной инфекции.
Инструментальная диагностика
Легкие исследуют не путем «просвечивания» грудной клетки, а с помощью вспомогательных медицинских инструментов и приборов.
Бронхоскопия
Визуальное обследование трахеи и бронхов с помощью специального оптического прибора — бронхоскопа. Результаты этого обследования важны, когда у пациента выражены признаки воспалительного или гнойного заболевания легких. Плюс бронхоскопии в том, что врач во время процедуры может взять образец ткани на биопсию.
Торакоскопия
Высокоточный инвазивный метод обследования и хирургического лечения легких с применением эндоскопической техники. Эндоскоп представляет собой гибкую трубку диаметром 0,7 - 3 см, оснащенную микровидеокамерой и светодиодом. Доступ к плевре легких осуществляется через небольшой надрез в области грудной клетки рядом с подмышечной впадиной. Процедура проводится под анестезией.
Торакоскопия — не самый простой и приятный метод обследования, однако он обладает высокой информативностью и позволяет сразу выполнить необходимые хирургические манипуляции: удалить кисты и лишнюю жидкость из перикарда, рассечь спайки, прижечь свищи, взять образец ткани на биопсию.
Торакоскопия легких назначается пациентам, у которых выявлены подозрительные новообразования, метастазы или увеличенные лимфоузлы, а также при экссудативном плеврите, причина которого до конца не ясна.

Спирометрия (спирография)
Метод широко распространен в пульмонологии, поскольку его проходят для непосредственно функциональной оценки легких. Спирометрия показывает общий объем легких, скорость и глубину вдоха, его резервный объем и т.д. Обследование проходят при ХОБЛ и эмфиземе, чтобы определить степень заболевания.
Спирометр представляет собой небольшой аппарат с трубкой и зажимом для носа. Пациент вдыхает и выдыхает в трубку настолько интенсивно и глубоко, насколько это возможно. Врач регистрирует и интерпретирует показатели.
Лабораторная диагностика
Лабораторные анализы позволяют определить наличие тех или иных бактерий, вирусов или грибков в организме человека. Для этого у пациента берут кровь, мазок из носоглотки, мочу и др. Образец биоматериала исследуют с применением специального оборудования. С помощью лабораторной диагностики определяют состав крови, различные биомаркеры, антитела и др.
Цель клинического анализа мокроты из трахеи, бронхов и легких — выявить, какие патогенные организмы в дыхательных путях человека провоцируют образование слизи и лейкопению. В норме у здорового человека мокрота при кашле не отделяется.
При анализе врач-лаборант учитывает и другие факторы, например, количество и цвет мокроты. В мокроте могут присутствовать гной (скопления лейкоцитов), кровь, воспалительный экссудат.
Если исследование мокроты под микроскопом не выявило бактерий или других патогенных микроорганизмов, это не значит, что инфекции нет. Пациенту в этой связи может быть рекомендовано дополнительное обследование.

Биопсия (плевральная пункция)
Биопсия (или гистологическое исследование) — это чрескожный забор образца плевры для исследования в лаборатории. Диагностика позволяет определить возбудителя туберкулеза, а также отличить злокачественное новообразование от доброкачественного. Биопсия проводится хирургом (как торакоскопия) или пульмонологом. Процедура не требует подготовки. Для гистологического исследования обычно берут 3 образца материала за 1 прокол кожи.
Мы перезвоним, подберём удобное для записи время и ответим на вопросы.
Оператор обрабатывает входящие заявки с 8:00 до 22:00
Нажимая на кнопку, вы даете согласие на обработку персональных данных в соответствии с Федеральным законом от 27.07.2006 г. № 152-ФЗ «О персональных данных».
Если вы оставили ее с 8:00 до 22:00, мы перезвоним вам для уточнения деталей в течение 15 минут.
Что показывает КТ грудной клетки, подготовка, показания и противопоказания

КТ органов грудной клетки - усовершенствованный способ рентгенографической визуализации, который использует излучение для создания детальных изображений грудины, грудино-ключичных суставов, ребер, прилежащих мягких тканей и органов (в первую очередь, легких).
Исследование проводят, если после выполненной обычной рентгенографии причина жалоб осталась неясной или есть подозрение на патологический процесс в данной области. Компьютерная томография органов грудной клетки может быть выполнена в качестве альтернативы МРТ, если у пациента есть противопоказания к проведению магнитно-резонансного сканирования. Для лучшей визуализации возможно введение контрастного вещества. Основным преимуществом КТ является его способность одновременно демонстрировать кости, мягкие ткани (при контрастировании) и кровеносные сосуды.
Что показывает КТ грудной клетки

Мультиспиральная КТ грудной клетки, 3D-реконструкция
Специалисты выделяют в средостении три области: центральное (сосудистое пространство с перикардом и его содержимым, сосудами и лимфатическими узлами), переднее (жировая клетчатка, вилочковая железа, внутренние грудные артерии и лимфоидные ткани) и заднее (трахея, пищевод, нисходящая часть грудной аорты, лимфоузлы и паравертебральные пространства грудной клетки). Соответственно, все патологические процессы, которые протекают в данных зонах, могут быть видны.
Грудина, ребра и их сочленения - основные структуры передней стенки грудной клетки - подвержены различным анатомическим аномалиям и патологическим процессам, которые в некоторых случаях требуют лечения. Врач обосновано направит на диагностическую процедуру, если у пациента имеет место необъяснимый длительный кашель, загрудинные боли, кровохарканье, увеличение регионарных лимфоузлов, ограничение в движении плеча, скованность в области грудного отдела позвоночника и др. КТ органов грудной клетки и средостения может показать следующие изменения:
Остеоартроз (остеоартрит) - распространенная патология, затрагивающая чаще грудино-ключичные суставы. На компьютерной томограмме, в отличие от рентгенограммы, можно увидеть субхондральный склероз, кисты, сужение суставной щели и изменения в волокнистой хрящевой ткани диска. Серонегативные артриты, подагра и некоторые иные заболевания также могут затрагивать соединения отделов грудины между собой и с окружающими костными структурами, что убедительно видно на КТ.
Ранняя диагностика септического артрита грудино-ключичного сустава важна для своевременного начала лечения, так как существует высокий риск осложнений - целлюлита, остеомиелита, медиастинита, септического шока. В запущенных случаях можно увидеть абсцесс и формирование свищевого хода. Изменения, которые видны при КТ органов грудной клетки, включают воспалительные процессы в твердых структурах (разрушение суставных поверхностей, расширение суставной щели), в органах и тканях (диффузная инфильтрация, скопление жидкости, газа, размытость границ, реактивное увеличение лимфоузлов). Осложнившуюся пневмонию, плеврит, абсцесс легкого и мягких тканей грудной клетки можно диагностировать с помощью КТ. Исследование также показывает изменения со стороны сердца и клапанного аппарата.
Острые и травматические состояния.
В результате сильного физического воздействия (чаще - вследствие ДТП) возникают один или несколько переломов грудины. Компьютерная томография позволяет диагностировать сочетанные травмы (повреждения ребер, грудного отдела позвоночника, легких и сердца) и осложнения (легочные ателектазы, гемо- и пневмоторакс, гемоперикард). Спонтанные переломы грудины возникают при наличии новообразования (множественная миелома, метастазирование), остеопороза и могут имитировать острые коронарные заболевания. С помощью КТ грудной клетки возможна диагностика врожденных аномалий сосудов или приобретенных патологий: тромбоэмболии легочной артерии, диссекции аорты и пр. По данным КТ ОГК выявляют причины ишемии, дисфункцию сердечных клапанов.
После выполнения стернотомии (операция обеспечивает лучший доступ к сердцу) есть вероятность осложнений: расхождения краев раны, вторичный остеомиелит грудины или ребер, медиастинит и медиастинальная гематома, плевральный выпот. После хирургических вмешательств на сердце и сосудах могут развиться неблагоприятные последствия (инфицирование электродов кардиостимулятора, инфекционно-воспалительные осложнения и пр.). Эти состояния с помощью КТ дифференцируют с нормальными послеоперационными изменениями. У таких пациентов выполняют компьютерное сканирование в динамике. Осложнения могут присутствовать и после вмешательств на легких и прочих структурах. В экстренных ситуациях преимущество КТ - быстрота получения результатов.
Новообразования и метастазирование.
Большинство неопластических процессов грудины носит метастатический характер, что объясняется прямым проникновением из соседних органов или гематогенным путем. Рак молочной и щитовидной желез, легкого, почки, толстой кишки и лимфомы - самые распространенные источники метастазов грудины. КТ грудной клетки с контрастом - золотой стандарт в диагностике рака легких, позволяет увидеть изменения на начальной стадии, при которой возможно радикальное лечение. Компьютерное сканирование показывает также новообразования средостения, которые многообразны по морфологии и генезу. Наиболее часто встречаются тимомы, кисты, нейрогенные опухоли, злокачественные лимфомы. С помощью сканирования при дисфагии можно предположить рак пищевода, но во всех случаях окнчательный диагноз подтверждает морфологическое исследование.
Нередко пациенты задают вопрос: “Что сделать - КТ или МРТ органов грудной клетки?” К каждому исследованию есть свои показания и противопоказания, но способы часто являются взаимодополняющими. Специалисты диагностического центра могут подсказать, что предпочтительнее в каждом конкретном случае, но лучше, если на руках будет направление от лечащего врача.
Как делают КТ органов грудной клетки

Положение пациента во время КТ грудной клетки
На диагностическую процедуру необходимо предварительно записаться, но возможно выполнение в день обращения, по жизненным показаниям. Современные КТ-сканеры могут исследовать большие участки тела всего за несколько секунд, что особенно подходит для пациентов, испытывающих трудности с длительной неподвижностью и маленьких детей. Рентген-техник размещает пациента на столе, для обеспечения неподвижности возможно использование фиксирующих ремней и подушек. Излишняя мобильность приводит к появлению размытости на изображениях. Наблюдение за ходом процедуры ведется из смежного кабинета, через стекло. Для экстренных случаев есть кнопка связи с персоналом. Стол с пациентом скользит вглубь томографа, вокруг тела начинает вращаться множество рентгеновских датчиков, передавая изображения поперечного сечения грудной клетки на экран монитора. Снимки с помощью специальной компьютерной программы могут быть переформатированы в другие плоскости. Полученные в результате диагностики данные легко перенести на любой носитель или распечатать. Неприятных ощущений во время КТ органов грудной клетки и средостения нет, технический шум, который производит работающее оборудование, можно нивелировать, если воспользоваться наушниками. Сканирование длится менее минуты, вся процедура с подготовкой и укладкой занимает не более получаса.
Для улучшения визуализации в некоторых случаях (преимущественно, в диагностике злокачественных новообразований и для оценки динамики после проведения химиолучевой терапии) выполняют КТ органов грудной клетки с контрастом. Препарат вводят внутривенно, перед этим обязательно оценивают уровень креатинина в крови. Усиленная радиофармпрепаратом компьютерная томография помогает уточнить диагноз при туберкулезе (количество очагов, их расположение, состояние лимфоузлов), но окончательная верификация происходит после оценки результатов комплексного обследования (пробы Манту, диаскинтеста, и, при необходимости, биопсии). Воспаление и повреждение паренхимы легких обычно хорошо видны на КТ без контрастного усиления. Если есть опасения по поводу осложнений, радиофармпрепарат может помочь дополнительно определить степень выраженности патологического процесса.
КТ органов грудной клетки детям проводят исключительно по жизненным показаниям в специальных диагностических центрах при педиатрических клиниках.
Подготовка к исследованию

Перед прохождением диагностики убедитесь в отсутствии противопоказаний
Каких-либо длительных мероприятий подготовка к КТ грудины не подразумевает, для нативного исследования достаточно выбрать удобную одежду без металла, снять украшения. Если предстоит введение контрастного вещества, за 40-50 минут до начала процедуры необходимо неплотно перекусить, что поможет предотвратить или уменьшить вегетативные реакции (легкую тошноту, слюнотечение, головокружение). Пациенты, страдающие сахарным диабетом и принимающие Метформин, по согласованию с эндокринологом должны отказаться от препарата за 48 часов до процедуры. Во время лактации рекомендуют сделать запас молока на два кормления.
Показания и противопоказания к КТ грудины
КТ грудины входит в компьютерное сканирование грудной клетки. Диагностика не является рутинным методом обследования и выполняется, если причина заболевания остается неясной или изменения на рентгенограммах требуют уточнения.
Перечислим основные показания к КТ грудины и грудной клетки:
подозрение на патологический процесс в легких, плевре, сердце, грудине, суставах, средостении;
пред- и послеоперационное обследование;
определение зоны для лучевого воздействия при злокачественных новообразованиях соответствующей области;
отслеживание динамики после проведенного лечения.
Противопоказания к КТ грудины и грудной полости
Современная аппаратура позволяет минимизировать лучевую нагрузку по сравнению с обычной рентгенографией в 1,5-2 раза: КТ ОГК безопасна для большинства людей. Исключение - беременные женщины и дети в возрасте до 14 лет. По техническим причинам диагностическая процедура невыполнима у пациентов с выраженным ожирением (выше 150 кг).
Противопоказания к выполнению контрастирования:
хроническая почечная недостаточность с повышением уровня креатинина;
Введение индикаторного препарата недопустимо, если во время или после предыдущего контрастирования развилась серьезная реакция гиперчувствительности по типу отека Квинке или анафилаксии. Небольшая тошнота, металлический привкус, головокружение, приливы жара рассматриваются как вариант нормы и не являются противопоказаниями к КТ с усилением.
Фото томографии грудной клетки
Расшифровка снимков происходит в тот же день. Полученные изображения анализирует врач-рентгенолог, который и выдает заключение. Определить верный диагноз непросто, ведь среди нескольких десятков оттенков черного, серого и белого необходимо вычленить несоответствующий норме и интерпретировать результат. Представим Вашему вниманию несколько фото томографии грудной клетки:

КТ без контраста у пациента с интерстициальным заболеванием легких в анамнезе и трансплантацией правого легкого показывает суженный участок анастомоза правого бронха (красная стрелка). Собственное левое легкое уменьшено в размерах, с признаками бронхоэктазов, бронхиолоэктазов (черная стрелка). Сужение центрального дыхательного пути на выдохе у трансплантированного легкого (синяя стрелка).

Выпот (красные стрелки) в обеих плевральных полостях.
КТ органов грудной клетки, что показывает, с контрастом или без

КТ органов грудной клетки - высокоинформативное рентгенологическое исследование, которое позволяет установить диагноз в самых тяжелых случаях. Врач назначает компьютерное сканирование, если есть жалобы со стороны сердца, легких, костно-суставных структур данной области, подозрение на опухолевый процесс и пр. КТ грудной клетки может выполняться нативно (без усиления), этого достаточно для оценки легких, но необходимость четкой визуализации сосудов, новообразований и степени их инвазии (проникновения в соседние ткани) подразумевает введение контрастного препарата.
Что показывает КТ
КТ органов грудной клетки показывает патологические процессы в средостении, легких, последствия травм, состояние лимфоидной ткани, индивидуальные анатомические особенности, которые помогают в планировании операции и пр. С помощью КТ можно наблюдать за болезнью в динамике, в том числе после выполненной терапии.
МРТ или КТ органов грудной клетки
Часто пациентов волнует вопрос: “Что лучше - КТ или МРТ?” Специалисты считают, что эти два исследования дополняют друг друга. Компьютерное сканирование подразумевает использование рентгеновского облучения, а при МРТ изображения получают благодаря магнитному полю. Лучевая нагрузка на организм нежелательна в период гестации и в детском возрасте до 14 лет, а магнитно-резонансное обследование невозможно сделать пациентам с установленными имплантами (кардиостимуляторами, инсулиновыми помпами, ортопротезами и пр.). КТ длится несколько минут, что делает ее незаменимой в ургентных ситуациях - при травмах, кровотечении, сердечно-сосудистых катастрофах.
В КТ органов грудной клетки входит оценка следующих органов и структур:
трахеи, бронхов, легких и плевры;
сердца и сосудов;
грудины, ребер и грудного отдела позвоночника;
Эти же структуры видны на МР-томограммах, но в диагностике патологий костной ткани КТ остается исследованием выбора.

В клинике “Магнит” установлен современный и безопасный томограф Siemens Somatom Emotion (16-срезовой)
В назначенное время пациента укладывают на стол томографа в горизонтальное положение. Для обеспечения неподвижности могут использовать фиксирующие ремни и валики, это необходимо для предотвращения артефактов (дефектов) на пленках, которые затрудняют диагностику. Если КТ органов грудной клетки (ОГК) выполняют с контрастированием - вводят внутривенно фармпрепарат одномоментно или болюсно (с помощью инжектора, который подает усилитель в определенные фазы исследования).
Стол перемещает пациента вглубь томографа, внутри кольца которого вокруг исследуемой области начинают вращаться датчики, улавливающие ответ органов и систем на ионизирующий поток частиц, испускаемых лучевой трубкой. Данные передаются на компьютер, а специальная программа выстраивает изображения. Современная МСКТ (мультиспиральная компьютерная томография), использующая множество детекторов, позволяет минимизировать лучевую нагрузку, что делает безопасным прохождение обследования для большинства пациентов. Болевых ощущений нет, для нивелирования механического шума от работы оборудования можно воспользоваться наушниками. Общение с персоналом проходит по громкой связи, под рукой есть ”тревожная кнопка”. Исследование занимает 15-20 минут, после КТ органов грудной клетки пациент может заниматься привычными делами.
КТ органов грудной клетки при туберкулезе

Очаговые изменения на КТ легких, подозрительные на туберкулезное поражение (выделено красным)
Туберкулез поражает пациентов любого возраста и пола, легкие вовлекаются в процесс наиболее часто. Болезнь считают социально опасной, так как при несвоевременной диагностике открытой формы (выделение микобактерий в окружающую среду при кашле) высок риск инфицирования окружающих людей. КТ органов грудной клетки при туберкулезе назначают в следующих ситуациях:
скрининговая рентгенография показала подозрительные на рассматриваемую патологию изменения;
у пациента положительные результаты лабораторных анализов на туберкулез (проба Манту, диаскинтест) при неоднозначных признаках на флюорограмме;
отслеживание динамики после проведенной специфической терапии;
в качестве предоперационной диагностики для выявления анатомических особенностей кровоснабжения и иннервации очагов, локализации патологии.
КТ органов грудной клетки с контрастированием

Болюсное контрастирование позволяет получить высококачественные томограммы, обеспечивая поступление препарата в нужные фазы исследования
Введение контраста при КТ - необходимая мера, если запланировано исследовать сосуды, мягкие ткани, выяснить местоположение опухоли и ее взаимоотношения с близлежащими структурами или метастазирование. МРТ для диагностики неопластических процессов предпочтительнее, но компьютерная томография помогает установить причину, когда к проведению магнитного сканирования есть противопоказания. КТ органов грудной клетки с контрастом способствует получению более информативных томограмм для оценки патологий сосудов. Выполнить дифференциальную диагностику заболеваний, анализируя результаты снимков, полученных после усиления, легче. Врачам часто приходится по данным КТ ОГК различать изменения, типичные для туберкулезной каверны, от раковой опухоли, бронхоплевральный свищ от абсцесса легкого, эмфизему от напряженной кисты и пр.
Подготовка к КТ органов грудной клетки с контрастом:
сдача анализа крови на уровень креатинина (можно сделать экспресс-методом за дополнительную плату перед исследованием в диагностическом центре “Магнит”);
перерыв в приеме сахароснижающих препаратов (Метформин и его аналоги) после разрешения эндокринолога;
отказ от лактации на 12 часов после выполнения КТ органов грудной клетки с введением контраста и предварительный запас молока на два последующих кормления.
КТ органов грудной клетки средостения
В центральной части грудной полости может развиваться множество патологий, которым необходима рентгенологическая оценка. КТ органов средостения - синонимичное название компьютерного сканирования грудной клетки: на томограммах видны все структуры, заключенные внутри реберно-грудинного каркаса.
КТ органов грудной клетки детям

КТ детям проводят в исключительных ситуациях, угрожающих жизни
Низкодозовую КТ органов грудной клетки детям выполняют по жизненным показаниям, если другие, не связанные с рентгеновским облучением, способы визуализации недоступны. Направление на КТ ребенку выдает консилиум врачей, чаще диагностику выполняют во время госпитализации в профильные педиатрические клиники. Основные причины для прохождения компьютерной томографии у детей:
опухоль органов грудной полости;
легочная форма туберкулеза;
диагностика врожденных пороков развития респираторных путей;
вдыхание инородного тела.
Обеспечение неподвижности во время исследования в несознательном возрасте требует выполнения седации. Диагностическая процедура проходит под наблюдением реаниматолога-анестезиолога.

Неплотный прием пищи предотвратит неприятные ощущения, которые могут развиться на введение контрастного препарата
Нативная КТ ОГК в экстренной ситуации может выполняться без всякой подготовки, но напомним о некоторых нюансах, которые сделают диагностическую процедуру более комфортной и информативной:
Одежда. Учитывая, что придется несколько минут лежать на столе, для удобства выберите просторное платье, свободные брюки и свитер. Если после КТ необходимо вернуться на работу, подразумевающую дресс-код, перед исследованием можно переодеться в специальный одноразовый халат. Все металлические детали (включая украшения, косточки бюстгальтера, пирсинг) приводят к появлению артефактов, поэтому их снимают перед процедурой.
Еда. Не стоит объедаться перед исследованием. На это есть две причины: переполненный желудок приведет к дискомфорту, сдавит органы грудной полости и сделает невозможным введение контраста из-за риска рвоты. Даже если Вы идете на КТ ОГК без усиления, часто после оценки нативных томограмм (при визуализации подозрительных объектов), может потребоваться контрастирование. Нельзя приходить на обследование голодным: фармпрепарат провоцирует развитие у некоторых людей вегетативных реакций: тошноты, слюноотечения, головокружения, поэтому оптимальным будет легкий завтрак.
Все выписные эпикризы, результаты предыдущих исследований и направление от врача возьмите с собой.
Показания и противопоказания

Врач перед направлением на рентгеновское исследование учитывает соотношение риска и пользы от диагностики
Показания к КТ органов грудной клетки - жалобы со стороны легких и органов и структур средостения, которые нельзя трактовать однозначно после оценки результатов первичных исследований: рентгенографии, УЗИ и пр. КТ ОГК можно сделать в качестве дополнительной диагностики, если есть:
кровохарканье, одышка, снижение дыхательных экскурсий грудной клетки, кашель, хрипы;
ограничение подвижности и боль в суставах плечевого пояса, грудного отдела позвоночника, пальпируемые образования и посттравматические боли в области грудной клетки, крепитации ребер (характерный хрустящий звук при переломах) и пр.;
затрудненность при глотании, в случае подозрения на стеноз пищевода;
загрудинные боли, усиливающиеся при движении, чувство нехватки воздуха;
увеличение шейных, надключичных и подключичных лимфатических узлов.
Противопоказания
Компьютерная томография не является преимущественным исследованием для беременных и детей младше 14 лет. КТ с контрастом стараются не проводить этой категории лиц и пациентам с отягощенным анамнезом, в который входит:
гиперфункция щитовидной железы;
аллергия на йодсодержащие вещества;
урологическая и нефрологическая патология с нарушением функции почек;
сердечно-сосудистые заболевания в стадии декомпенсации.
Результат КТ ОГК будет готов через 90-120 минут, в диагностическом центре “Магнит” в СПб полученные данные в сомнительных ситуациях оцениваются коллегиально. Представим на обозрение несколько томограмм, которые демонстрируют патологические процессы в грудной клетке:

КТ органов грудной клетки демонстрирует опухоль средостения (границы выделены маркерами)
КТ средостения что показывает

В диагностике заболеваний органов грудной полости часто используют инструментальные исследования. Одним из наиболее эффективных методов является КТ средостения с контрастом. Компьютерная томография позволяет визуализировать строение внутренних структур без инвазивных манипуляций. Исключение составляет внутривенное введение «окрашивающего» йодсодержащего раствора.

КТ средостения, аксиальная, сагиттальная и фронтальная проекции
Для исследования тканей используют ионизирующие потоки. В отличие от линейной рентгенографии, во время КТ заданную область можно сканировать на определенной глубине. В результате получают фотографии тонких (от 0,5 мм) срезов рассматриваемой зоны. Большей эффективностью отличается компьютерная томография твердых тканей (кости, хрящи) и полых органов. Для повышения информативности сканирования применяют болюсное усиление.
КТ средостения с контрастом назначают для визуализации мягких тканей, сосудистой системы, новообразований. Метод обеспечивает детальное изучение внутренних органов и анатомических структур грудной полости.
Что покажет КТ средостения?
Компьютерная томография визуализирует форму, размеры, особенности строения внутренних органов и морфологических образований грудной полости. На основании результатов КТ оценивают состояние трех отделов средостения:
Каждое пространство имеет условные границы и включает в себя определенные анатомические структуры. В протоколе исследования врач указывает изучаемый отдел с дальнейшим описанием состояния внутренних органов.

Метастатическое поражение легких
В зону сканирования при КТ средостения и грудной клетки входят:
сердце и перикард;
тимус (вилочковая железа);
трахея, бронхи, легкие;
восходящий отдел и дуга аорты;
верхняя и нижняя полые вены;
жировая клетчатка средостения;
легочные вены и артерии;
грудина и ребра;
грудной отдел позвоночника.
Костные структуры на снимках КТ имеют светлый оттенок, анатомические образования с низкой плотностью выглядят как затемненные участки.
Тимус на томограммах хорошо определяется в детском возрасте. После 25 лет начинается процесс замещения железы жировой тканью. Максимальная толщина анатомического образования у взрослых в норме не превышает 1,3 см.
Лимфатические узлы представляют собой обособленные мягкотканные элементы округлой формы. Патологические процессы приводят к увеличению размеров, иногда наблюдают слияние органов.
КТ средостения с контрастом показывает нарушения кровоснабжения грудной полости, сосудистые патологии, очаги ишемии и некроза. Метод позволяет выявить малейшие изменения структуры изучаемых органов. На снимках видны воспалительные, дегенеративные, неопластические явления костных элементов, эпителиальных оболочек, легочной ткани.
Компьютерная томография груди и шеи визуализирует проходимость воздухоносных путей, показывает наличие мокроты, инородных тел, образований в просвете трахеи и бронхов. На основании инструментального исследования оценивают объем поражения легких, функциональность дыхательной системы.

Пневмоторакс на снимке КТ (стрелка указывает на область, заполненную воздухом)
Томограммы отражают скопление газа в плевральной или грудной полости. При травмах по снимкам можно определить разрывы стенок кровеносных сосудов, очаги внутренних кровоизлияний и последствия геморрагий.
КТ средостения показывает, что происходит в области перикарда. Процедура позволяет оценить состояние камер, коронарных сосудов, определить степень функциональности сердечной мышцы
При наличии новообразования компьютерная томография помогает уточнить локализацию, размеры опухоли, определить характер онкологического процесса. На снимках с контрастированием хорошо видны:
особенности строения очага;
взаимодействие с окружающими здоровыми тканями.
В отношении костного каркаса оценивают однородность, форму твердых структур. По результатам сканирования определяют смещение морфологических элементов, нарушения целостности твердых тканей, дегенеративные явления.
Показания и противопоказания к КТ средостения
Компьютерную томографию грудной клетки используют в диагностике заболеваний дыхательной, сердечно-сосудистой, костно-мышечной систем. Поводом для аппаратного исследования служат характерные симптомы:
цианоз носогубного треугольника, пальцев рук и ног;
боли в грудной полости;
слабость, озноб, повышение температуры тела.
КТ назначают при наличии затемнений, расширении границ средостения и корней легких на рентгенограммах.
С помощью компьютерной томографии грудной полости диагностируют:
инфекционные поражения (туберкулез);
системные заболевания (саркоидоз, лимфогранулематоз);
дивертикулы или стеноз пищевода (кольца Шацкого);
лимфаденопатии (реактивные и инфекционные);
пневмо- и гемоторакс;
последствия травм грудной клетки;
диафрагмальные грыжи и пр.
Показанием для исследования служит необходимость оценки состояния средостения при подготовке к торакальной операции.
Туберкулез легких на КТ (множественные очаги)
Особенностью компьютерной томографии является лучевая нагрузка на организм пациента. Ограничениями к нативной процедуре служат:
ранний детский возраст;
состояние здоровья, исключающее применение рентгена (лучевая болезнь).
Противопоказания к контрастной процедуре связаны с использованием йодсодержащего раствора. Вещество может вызвать аллергию, влияет на работу выделительной и эндокринной систем.
КТ средостения с контрастом не назначают в случае:
почечной недостаточности - процесс выведения препарата усиливает нагрузку на выделительную систему;
индивидуальной непереносимости йода - возможно появление аллергической реакции;
гиперфункции щитовидной железы - введение контраста усиливает клинические признаки тиреотоксикоза;
терапии сахарного диабета препаратами на основе Метформина - одновременное применение с йодом провоцирует рост концентрации молочной кислоты и повышает нагрузку на почки.
При соблюдении ограничительных мер компьютерная томография не оказывает негативного влияния на организм пациента.
Как делают КТ средостения?
Для компьютерной томографии используют сложное оборудование. КТ-аппарат состоит из передвижного стола и кольцевой части, внутри которой находятся излучатели и датчики.

Компьютерная томография легких и органов средостения
Пациент ложится на транспортер лицом вверх. Для повышения качества изображений необходимо соблюдать неподвижность на протяжении всего сеанса. Смена положения тела приводит к искажению картины, появлению артефактов на снимках.
Стол с пациентом перемещается внутри кольца томографа. Сканирующие элементы движутся по кругу, делая за полный оборот несколько снимков. Процедура получила название мультиспиральной компьютерной томографии. МСКТ обеспечивает:
снижение лучевой нагрузки;
сокращение времени сканирования;
повышение качества изображений.
В результате получают фотографии аксиальных срезов, с помощью которых достраивают сагиттальную и фронтальную проекции. Для уточнения локализации патологического очага и оценки взаимного расположения анатомических структур средостения реконструируют 3D-модель рассматриваемой зоны.

Вирусная (ковидная) пневмония на томограмме
КТ средостения и легких занимает от 5 до 10 минут. При использовании контрастного усиления продолжительность диагностической процедуры увеличивается. Инъекцию делают после серии нативных снимков. Сканирование приостанавливают, через внутривенный катетер пациенту вводят «окрашивающий» раствор. В течение 10-15 минут препарат заполняет просвет сосудов грудной полости, после чего сканирование продолжают.
КТ средостения с контрастом занимает не более получаса. Через 1-2 дня происходит полное очищение организма от следов йодсодержащего раствора.
Как подготовиться к КТ средостения?
Компьютерную томографию проводят по предварительной записи. На процедуру следует прийти за 10-15 минут до начала. При себе желательно иметь паспорт, полис, направление лечащего врача, результаты предыдущих обследований.
Перед КТ необходимо заполнить бумаги, снять украшения и аксессуары из железа, можно переодеться в удобный костюм или пижаму.
Нативная процедура не требует специальной подготовки. При наличии противопоказаний необходимо предупредить специалиста. Женщины, подозревающие беременность, проходят дополнительное обследование. При подтверждении гестации врач подберет альтернативный способ инструментальной диагностики.
КТ средостения с контрастом требует более тщательных подготовительных мер. Пациент сдает кровь на креатинин. Анализ должен быть свежим, давностью не более 7 дней. Некоторые клиники проводят экспресс-тестирование перед процедурой. Повышенное содержание креатинина свидетельствует о нарушении функциональности почек.
Больные сахарным диабетом до КТ средостения и легких с контрастом проходят консультацию у эндокринолога. При лечении Метформином препарат нужно отменить за 72 часа до процедуры. При необходимости пациенту на период обследования назначают аналогичное гипогликемическое средство.
При заболеваниях щитовидной железы с признаками гипертиреоза может потребоваться анализ на гормоны. Решение о необходимости данного обследования принимает врач-эндокринолог.
Диагностический центр «Магнит» проводит КТ средостения и легких с использованием современного 16-срезового томографа фирмы Siemens.

Трехмерная реконструкция грудной клетки
Как проходит исследование органов грудной клетки?
Рассказываем обо всех видах исследования органов грудной клетки: от КТ до торакотомии. Чем они отличаются? В каком случае какое исследование назначают?

Информацию из данного раздела нельзя использовать для самодиагностики и самолечения. В случае боли или иного обострения заболевания диагностические исследования должен назначать только лечащий врач. Для постановки диагноза и правильного назначения лечения следует обращаться к Вашему лечащему врачу.
С осмотром грудной клетки знакомы все. Некоторые люди проверяют органы грудной клетки регулярно из-за проблем со здоровьем, а кто-то ограничивается обязательной флюорографией раз в год для справки на работу. Однако, исследование органов грудной клетки бывает разное: это может быть рентген, КТ, эндоскопия и даже операция. Чем они отличаются, и в каком случае какой вариант назначают? Давайте разбираться.
Рентген при осмотре грудной клетки
Самый простой способ исследовать внутренние органы — сделать снимок при помощи специального оборудования. В зависимости от типа и мощности прибора снимки будут разного качества и глубины:
- Флюорография (ФЛГ). Цифровой или плёночный снимок лёгких. Снимок делают за счёт рентгеновского излучения очень малой дозы. Это самый распространённый тип исследований, достаточно безопасный даже для детей. Изображение лёгких получается пусть не очень чёткое, но вполне информативное. ФЛГ традиционно используют для профилактики туберкулёза.
- Рентген лёгких. Снимок получается более чёткий, чем при ФЛГ, за счёт высокой дозы облучения. Но из-за этого рентген нежелательно делать беременным женщинам и людям с ослабленным здоровьем.
- Ультразвуковое исследование. Абсолютно безопасный способ обследования. Технически его можно использовать для осмотра всех органов грудной клетки, но обычно с его помощью пытаются обнаружить жидкость в плевральной полости.
Для ФЛГ и рентгена вас попросят раздеться и встать перед устройством, которое сделает снимок. Нужно снять все украшения с шеи, так как на снимке они будут перекрывать тело.

Для ультразвукового исследования тело покрывают гелем, чтобы датчик лучше скользил, и исследуют им нужный участок груди.
Использование томографии
Томография — один из ключевых неинвазивных методов осмотра грудной клетки. Его несомненные преимущества: высокое качество изображения и практически полная безопасность для пациента. Для исследования органов грудной клетки используют два типа томографии:
- Магнитно-резонансная томография. Позволяет детально обследовать всю сердечно-сосудистую и дыхательную системы. Противопоказана людям с большим лишним весом — стол аппарата рассчитан на 120-130 кг. Кроме того, она может навредить тем, у кого стоят металлические импланты и кардиостимуляторы. Но МРТ безопасна для детей, беременных и кормящих матерей, так как в ней не используется рентгеновское излучение.
- Компьютерная томография. С её помощью получают объёмную модель внутренних органов. КТ работает по принципу рентгена, зато не имеет других противопоказаний, кроме возраста и беременности.
В сети наших диагностических центров, перед проведением КТ вас попросят заполнить договор на оказание медицинских услуг, согласие на обработку персональных данных и анкету с информацией о состоянии вашего здоровья — последнее поможет врачу-рентгенологу сделать упор на важные моменты при исследовании.
Дальше вас будет сопровождать рентгенолаборант. Он расскажет вам о ходе исследования, после чего проводит в раздевалку. Обычно для проведения томографии не нужно раздеваться полностью: достаточно снять одежду с металлическими предметами (молниями и пуговицами), обувь, очки и украшения.
Вас проводят в кабинет, где вы ляжете на стол томографа. Лаборант будет наблюдать за ходом исследования. Так что если вам вдруг станет плохо, сможете попросить остановить исследование. Но если противопоказаний нет, пациент всегда чувствует себя комфортно. Всё, что от вас требуется: слушать команды лаборанта и задерживать дыхание в нужный момент. Если при выполнении МРТ нужно лежать неподвижно, то при КТ небольшие движения не будут искажать готовый снимок.
Если нужно провести исследование с контрастом, то после серии снимков лаборант введёт вам контрастное вещество внутривенно — количество зависит от вашего веса. После этого процедуру возобновляют на пару минут.

Всё исследование длится не более пятнадцати минут. После этого лаборант вновь заходит в кабинет, помогает вам подняться и провожает в раздевалку. Заключение с расшифровкой готово сразу после проведения процедуры.
Эндоскопия в исследованиях лёгких
В рамках эндоскопии, через естественные пути в организм вводят инструмент с камерой. Изображение хорошего качества передаётся на монитор, благодаря чему можно рассмотреть нужный участок.
Бронхоскопия — единственный метод безоперационной эндоскопии грудной клетки. Она используется как для диагностики, так и для лечения. С помощью эндоскопа можно удалить слизь, гной и инородные тела, ввести лекарственные препараты, а также взять мокроту и образцы ткани для анализа.
Исследование нельзя проходить при дыхательной недостаточности, обострении астмы, аневризме, инфаркте и нарушениях свёртываемости крови. А перед обследованием вам обязательно назначат анализы:
- флюорографию,
- ЭКГ,
- анализы крови на ВИЧ и гепатиты,
- коагулограмму.
Исследование органов грудной клетки с помощью операций
Разумеется, ни один врач не будет проводить полостную операцию просто для осмотра. Но есть два вида эндоскопии, которые выполняются под общим наркозом через разрезы грудной клетки:
- Торакоскопия — исследование поверхности лёгких и плевральной полости. Через разрезы вводят эндоскоп и инструменты: можно взять образцы тканей и ввести необходимые лекарственные средства.
- Медиастиноскопия — осмотр средостении, который проводится для оценки опухоли лёгких или установки причины увеличения лимфатических узлов.
Нельзя не упомянуть пункции плевральной полости и биопсию плевры. Доктор вводит в тело иглу и берёт на анализ кусочек ткани или плевральную жидкость.

Более серьёзный вид оперативного обследования — торакотомия. Врач самостоятельно осматривает все внутренние органы, вскрыв грудную клетку. Существенный плюс торакотомии — возможность взять образцы любых тканей на обследование и оперативное выполнение лечения.
В каких случаях назначают обследования
Чем проще исследование органов грудной клетки, тем чаще его назначают. Флюорографию рекомендуют проходить раз в год для профилактики. Если по работе вы контактируете с людьми и продуктами питания, результаты ФЛГ потребуются для доступа к работе.
Другие виды обследований без серьёзных показаний вам никто не назначит. ОРЗ или ангина — не повод делать эндоскопию и МРТ. При пневмонии могут назначить томографию и бронхоскопию. А другие виды исследований назначаются при серьёзных и опасных симптомах:
- затемнения на рентгеновских снимках,
- инородное тело в дыхательных путях,
- подозрение на онкологию,
- кровохарканье,
- абсцессы и кисты в дыхательных путях и лёгких,
- воспаления плевры,
- увеличение лимфатических узлов,
- травмы и нагноения в грудной клетке.
Противопоказаний у исследований совсем немного:
- у рентгена и КТ — беременность и период грудного вскармливания;
- у МРТ — избыточная масса тела, металлические имплантаты, кардиостимуляторы, клаустрофобия;
- у бронхоскопии — обострения астмы;
- у всех видов эндоскопии — нарушенная свёртываемость крови, внутренние кровотечения, острая лёгочная недостаточность, инфаркты и перитонит.
Исследования необходимы при серьёзных заболеваниях, так как без них будет тяжело установить причины недугов. Кроме того, почти все виды обследований позволяют сразу же провести лечение, если оно возможно. Поэтому, несмотря на сложность их проведения, они пользуются большой популярностью при всех болезнях дыхательной системы.
Читайте также:
- Плевральная полость. Механизм вентиляции легких.
- Повреждение мениска коленного сустава. Диагностика и лечение
- Лечение артериальной гипоксемии. Что делать при артериальной гипоксемии и цианозе?
- Пример операции при ранении диафрагмы при проникающем ранении брюшной полости
- Проявление гипертрофии отделов сердца на ЭКГ. Формы зубцов электрокардиограммы при гипертрофии
